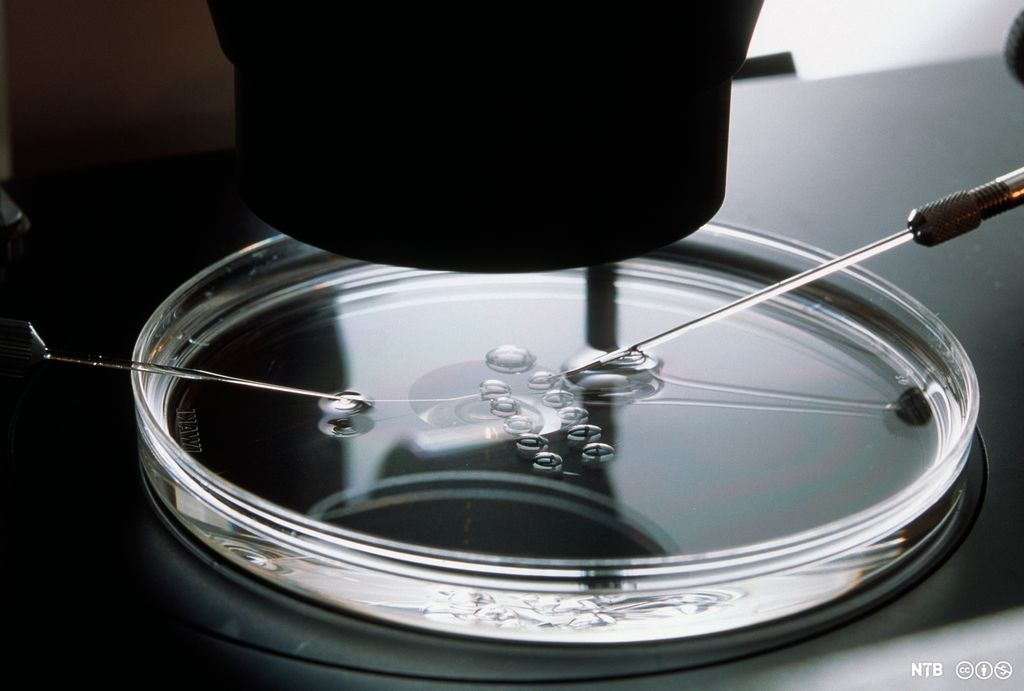
Cellekjernen i en eggcelle fjernes i ei petriskål under mikroskopet. Foto.

Genterapi

Hva er genterapi?
Genterapi innebærer å overføre nytt genetisk materiale (DNA eller RNA) eller endre pasientens egne gener for å behandle sykdom. Genterapi brukes for å behandle sykdommer som skyldes genfeil. En genfeil kan ha ulike konsekvenser, for eksempel følgende:
- Cellene ikke kan produsere et funksjonelt protein.
- Cellene produserer feil type proteiner.
- Cellene produserer proteiner med feil som kan være skadelige.
- Genet blir overaktivt, slik at cellene produserer skadelige mengder av et gitt protein.
I slike tilfeller kan man overføre friske gener til en pasient i håp om at de nye genene vil overta funksjonen og erstatte de ødelagde genene hos pasienten. En annen mulighet er å hente ut pasientens egne celler og reparere genfeilen ved hjelp av genredigering, gjerne med CRISPR, og deretter sette cellene tilbake i pasienten. Det er også mulig å skru av overaktive gener eller overføre gener som gir cellene nye sykdomsbekjempende egenskaper.
Overføring av genetisk materiale
Den største utfordringen i utviklingen av genterapi som behandlingsform har vært å få transportert nye gener inn i en pasient. Genetiske molekyler er for store til at de kan krysse cellemembranen. Derfor må de overføres til cellene på en annen måte.

Ett alternativ er å bruke en vektor, som fungerer som en transportør av genetisk materiale. I genterapi er vektoren et virus som har blitt modifisert slik at virusets egne gener, som vanligvis gir sykdom hos mennesker, er byttet ut med det friske genet vi ønsker å overføre til pasienten. Viruset kan da infisere cellene til pasienten med de friske genene. Når vi bruker virus, kan de friske genene permanent integreres i pasientens eget arvestoff.
En annen mulighet er å overføre de friske genene ved å pakke dem inn i små fettpartikler som smelter sammen med cellemembranen til pasientens egne celler. Det er også mulig å overføre genene mekanisk ved hjelp av en elektrisk puls som lager hull i cellene, slik at gener kan passere. Eller man kan bruke genpistol til å skyte friske gener inn i ønskede celler. I disse tilfellene vil ikke genterapien være permanent, bare gi midlertidige endringer.
Genterapi gis til pasienten ved at virus, fettpartikler eller genetisk materiale sprøytes inn i blodbanen eller direkte i vevet som skal behandles. Eventuelt kan det sprøytes inn i pasientens egne celler på et laboratorium og deretter settes inn igjen i pasienten.
Medisinsk behandling – aldri uten risiko for bivirkninger
Tidligere ble genterapi ansett som teknisk vanskelig og risikabelt, men i dag regnes det som en relativt trygg behandlingsform på lik linje med andre medisinske behandlinger.

Det kan likevel oppstå bivirkninger hvis pasientens immunsystem angriper det tilførte viruset eller proteinet som produseres av det friske genet. Dette vil redusere effekten av behandlingen og føre til at pasienten blir syk. Pasienter som behandles med genterapi, får derfor immundempende medisiner for å redusere aktiviteten til immunforsvaret og dermed også risikoen for disse bivirkningene.
En annen ulempe ved genterapi er at viruset setter inn det genetiske materialet på et tilfeldig sted i pasientens eget arvestoff. Dette kan medføre at viktige gener hos pasienten blir skrudd av eller på. Det kan igjen føre til uforutsette bivirkninger, for eksempel utvikling av kreft.
Status – hvor langt har forskningen kommet?
ADA-SCID er en alvorlig genetisk sykdom som svekker immunforsvaret så dramatisk at pasientene må leve helt isolert fra omverden. I 1990 ble genterapi for første gang brukt til å behandle en fire år gammel jente med nettopp denne sykdommen. I 2016 ble genterapi for ADA-SCID godkjent som medisinsk behandling i EU.


I 2018 fikk norske pasienter for første gang tilbud om genterapi gjennom det offentlige helsevesenet. Den aktuelle behandlingen heter Kymriah og brukes mot enkelte typer blodkreft. Ved denne typen behandling modifiseres pasientens eget immunforsvar til å drepe kreftceller. Dette skjer ved at man tar ut immunceller fra pasienten. Deretter genmodifiseres immuncellene, slik at de kan gjenkjenne og videre drepe kreftceller når de settes tilbake i pasienten.
I 2021 er det genterapi under utvikling for en rekke sykdommer, blant annet hemofili, blindhet, blodsykdommer, immunsvikt og ulike former for kreft. Det forventes at genterapi vil få stor betydning innen medisinsk behandling i framtida.
Genterapi – hvor skal grensen gå?
Gener påvirker ikke bare sykdom. De gir oss også mulighet til å foreta genetiske endringer av andre egenskaper. Hva med å forbedre prestasjonsevnen ved å øke muskelmassen eller oksygenopptaket? Eller hva med å stoppe aldringsprosessen eller øke intelligensen? Hvor skal grensen gå?
Gendoping

Gendoping er bruk av medisinsk genterapi på friske idrettsutøvere med det formål å øke prestasjonsevnen. Gendoping kan være sterkt prestasjonsfremmende når det gjelder både utholdenhet og muskelstyrke. Ved å øke aktiviteten på EPO-genet vil kroppen produsere flere røde blodceller, og oksygenopptaket vil øke. En annen mulighet er å øke aktiviteten til genet som produserer proteinet follistatin, som gir økt muskelmasse. Dette har man allerede gjort for pasienter med muskelsvikt.
Evig ung

Aldring er en del av livsprosessen til alle organismer. Med genterapi kan vi øke levetida på stamcellene i kroppen ved å gjøre endringer på genet som koder for enzymet telomerase. En slik endring kan forsinke eller hindre aldringsprosessen i kroppen og kan blant annet brukes i behandling av alderdomsdemens. Kanskje kan vi i framtida leve til vi er 150 år?
Hva sier bioteknologiloven?
I den reviderte bioteknologiloven fra 2020 ble genterapi likestilt med annen medisinsk behandling av sykdom, og genterapi er blitt en del av sykdomsbehandlingen i det norske helsevesenet. Likevel finnes det begrensninger. I Norge og de fleste andre land i verden er det forbudt å gjøre arvelige genetiske endringer på mennesker. Dette innebærer genterapi på kjønnsceller og befruktede egg. Bruken av genterapi er med andre ord begrenset til behandling av kroppsceller hos allerede fødte individer.
Related content
E-forelesning som forklarer hvordan genterapi kan brukes til å behandle sykdom.
Web page at youtube.com
Kilde
Bioteknologirådet (2021, januar). Genterapi. Hentet 2. februar 2021 fra https://www.bioteknologiradet.no/temaer/genterapi/